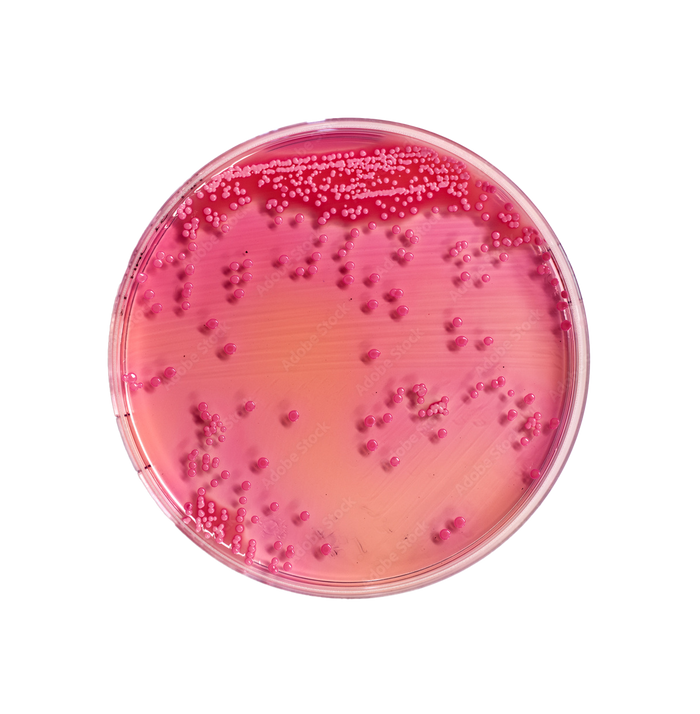

Was wissen Sie vielleicht noch nicht über Parodontitis?
Parodontitis ist eine chronische Entzündung des Zahnhalteapparats – also des Zahnfleischs, des Bindegewebes und des Kieferknochens, der die Zähne im Kiefer verankert. Sie entwickelt sich meist aus einer unbehandelten Zahnfleischentzündung, die sehr häufig durch eine bakterielle Dysbalance ausgelöst wird.
Doch was viele nicht wissen: In Ihrem Mund leben mehr als 700 verschiedene Bakterienstämme. Wie kann es also zu einer Infektion und Entzündung kommen? Der Auslöser ist eine Verschiebung im oralen Mikrobiom: Schädliche Bakterien wie Porphyromonas gingivalis gewinnen die Oberhand, während schützende Mikroorganismen zurückgedrängt werden.
Das Tückische daran: Parodontitis verläuft häufig schmerzarm, führt aber langfristig zu Zahnfleischrückgang, Knochenabbau und schließlich Zahnverlust.